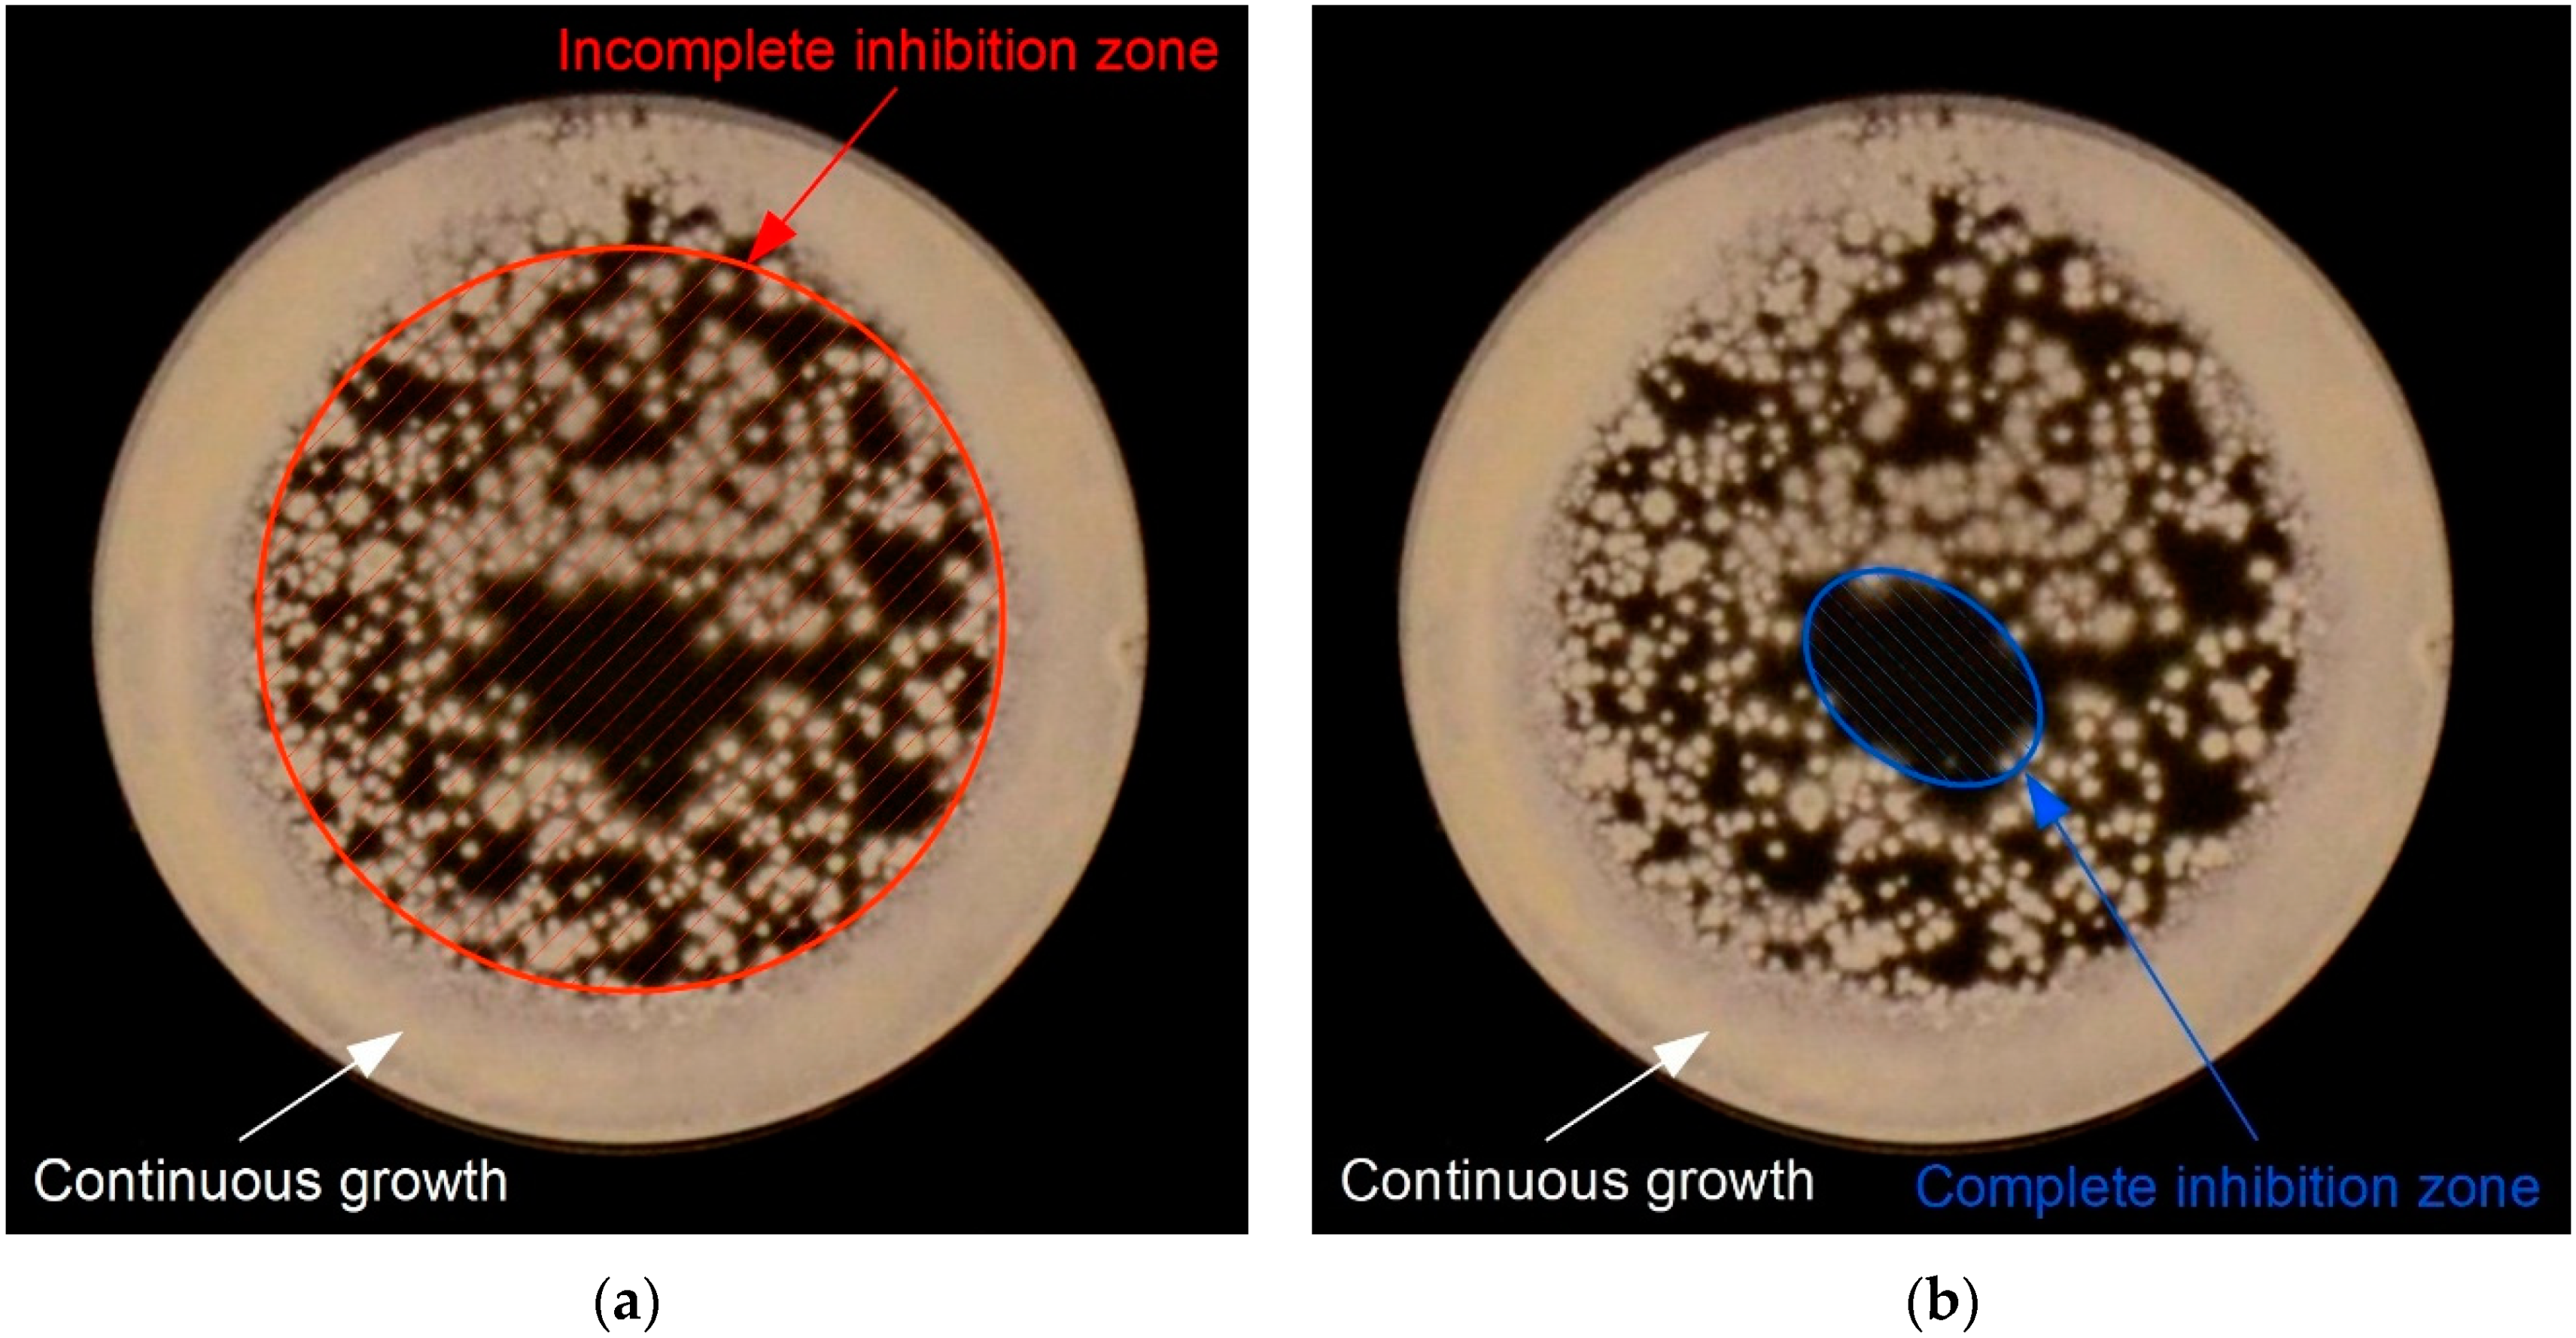
Molecules 27 00238 g008 Molecules 27 00238 g008

Non-Thermal Plasma Sources Based on Cometary and Point-to-Ring Discharges
Abstract
1. Introduction
2. Results
2.1. Electrical Properties of the Cometary and Point-to-Ring Discharges
2.2. Emission Properties of the Cometary and Point-to-Ring Discharges
2.3. Microbicidal Properties of the Cometary and Point-to-Ring Discharges
3. Discussion
4. Materials and Methods
4.1. Non-Thermal Plasma Generation
4.2. Electrical Properties of the Discharges
4.3. Emission Properties of the Discharges
4.4. Microbial Strains
4.5. Evaluation of Microbicidal Properties
5. Conclusions
Author Contributions
Funding
Institutional Review Board Statement
Informed Consent Statement
Data Availability Statement
Acknowledgments
Conflicts of Interest
Sample Availability
References
- Eichenberger, E.M.; Thaden, J.T. Epidemiology and mechanisms of resistance of extensively drug resistant Gram-negative bacteria. Antibiotics 2019, 8, 37. [Google Scholar] [CrossRef]
- Livermore, D.M. Antibiotic resistance in staphylococci. Int. J. Antimicrob. Agents 2000, 16, 3–10. [Google Scholar] [CrossRef]
- Magiorakos, A.P.; Srinivasan, A.; Carey, R.B.; Carmeli, Y.; Falagas, M.E.; Giske, C.G.; Harbarth, S.; Hindler, J.F.; Kahlmeter, G.; Olsson-Liljequist, B.; et al. Multidrug-resistant, extensively drug-resistant and pandrug-resistant bacteria: An international expert proposal for interim standard definitions for acquired resistance. Clin. Microbiol. Infect. 2012, 18, 268–281. [Google Scholar] [CrossRef] [PubMed]
- Mah, T.F.C.; O’Toole, G.A. Mechanisms of biofilm resistance to antimicrobial agents. Trends Microbiol. 2001, 9, 34–39. [Google Scholar] [CrossRef]
- Sodhi, N. New mechanism of resistance in a last-resort antibiotic. Austr. Veter. J. 2016, 94, 8–9. [Google Scholar]
- Spampinato, C.; Leonardi, D. Candida infections, causes, targets, and resistance mechanisms: Traditional and alternative antifungal agents. Biomed Res. Int. 2013, 2013, 204237. [Google Scholar] [CrossRef]
- Liao, X.; Li, J.; Suo, Y.; Ahn, J.; Liu, D.; Chen, S.; Hu, Y.Q.; Ye, X.Q.; Ding, T. Effect of preliminary stresses on the resistance of Escherichia coli and Staphylococcus aureus toward non-thermal plasma (NTP) challenge. Food Res. Int. 2018, 105, 178–183. [Google Scholar] [CrossRef]
- Scholtz, V.; Vaňková, E.; Kašparová, P.; Premanath, R.; Karunasagar, I.; Julák, J. Non-thermal Plasma Treatment of ESKAPE Pathogens: A Review. Front. Microbiol. 2021, 12, 737635. [Google Scholar] [CrossRef]
- Bruggeman, P.; Iza, F.; Brandenburg, R. Foundations of atmospheric pressure non-equilibrium plasmas. Plasma Sources Sci. Technol. 2017, 26, 123002. [Google Scholar] [CrossRef]
- Ehlbeck, J.; Schnabel, U.; Polak, M.; Winter, J.; von Woedtke, T.; Brandenburg, R.; von dem Hagen, T.; Weltmann, K.D. Low temperature atmospheric pressure plasma sources for microbial decontamination. J. Phys. D: Appl. Phys. 2010, 44, 013002. [Google Scholar] [CrossRef]
- Nehra, V.; Kumar, A.; Dwivedi, H.K. Atmospheric non-thermal plasma sources. Int. J. Eng. 2008, 2, 53–68. [Google Scholar]
- Tendero, C.; Tixier, C.; Tristant, P.; Desmaison, J.; Leprince, P. Atmospheric pressure plasmas: A review. Spectrochim. Acta B 2006, 61, 2–30. [Google Scholar] [CrossRef]
- Yousfi, M.; Merbahi, N.; Sarrette, J.P.; Eichwald, O.; Ricard, A.; Gardou, J.P.; Ducasse, O.; Benhenni, M. Biomedical Engineering Book 4; INTECH Open Access Publisher: London, UK, 2011. [Google Scholar]
- Fridman, A.; Chirokov, A.; Gutsol, A. Non-thermal atmospheric pressure discharges. J. Phys. D: Appl. Phys. 2005, 38, 1–24. [Google Scholar] [CrossRef]
- Khun, J.; Scholtz, V.; Hozak, P.; Fitl, P.; Julak, J. Various DC-driven point-to-plain discharges as non-thermal plasma sources and their bactericidal effects. Plasma Sources Sci. Technol. 2018, 27, 065002. [Google Scholar] [CrossRef]
- Laroussi, M.; Akan, T. Arc-free atmospheric pressure cold plasma jets: A review. Plasma Process. Polym. 2007, 4, 777–788. [Google Scholar] [CrossRef]
- Winter, J.; Brandenburg, R.; Weltmann, K.D. Atmospheric pressure plasma jets: An overview of devices and new directions. Plasma Sources Sci. Technol. 2015, 24, 064001. [Google Scholar] [CrossRef]
- Brandenburg, R. Dielectric barrier discharges: Progress on plasma sources and on the understanding of regimes and single filaments. Plasma Sources Sci. Technol. 2017, 26, 053001. [Google Scholar] [CrossRef]
- Fridman, A.; Nester, S.; Kennedy, L.A.; Saveliev, A.; Mutaf-Yardimci, O. Gliding arc gas discharge. Prog. Energ. Combust. 1999, 25, 211–231. [Google Scholar] [CrossRef]
- Lebedev, Y.A. Microwave discharges at low pressures and peculiarities of the processes in strongly non-uniform plasma. Plasma Sources Sci. Technol. 2015, 24, 053001. [Google Scholar] [CrossRef]
- Scholtz, V.; Julák, J. The cometary discharge, a possible new type of DC electric discharge in air at atmospheric pressure, and its bactericidal properties. J. Phys. Conf. Ser. 2010, 223, 012005. [Google Scholar] [CrossRef]
- Scholtz, V.; Julák, J. Plasma jetlike point-to-point electrical discharge in air and its bactericidal properties. IEEE Trans. Plasma Sci. 2010, 38, 1978–1980. [Google Scholar] [CrossRef]
- Julák, J.; Scholtz, V.; Kvasničková, E.; Kříha, V.; Jíra, J. Bactericidal properties of cometary discharge with inserted grid. In Book of Abstracts, Proceedings of the 4th International Conference on Plasma Medicine, Orleans, France, 17–21 June 2012; Mikikian, M., Rabat, H., Robert, E., Pouvesle, J.-M., Eds.; International Society for Plasma Medicine: Orléans, France, 2012. [Google Scholar]
- Julák, J.; Scholtz, V. Decontamination of human skin by low-temperature plasma produced by cometary discharge. Clin. Plasma Med. 2013, 1, 31–34. [Google Scholar] [CrossRef]
- Paldrychova, M.; Vankova, E.; Scholtz, V.; Julak, J.; Sembolova, E.; Mat’atkova, O.; Masak, J. Effect of non-thermal plasma on AHL-dependent QS systems and biofilm formation in Pseudomonas aeruginosa: Difference between non-hospital and clinical isolates. Aip Adv. 2019, 9, 055117. [Google Scholar] [CrossRef]
- Scholtz, V.; Julák, J.; Kříha, V. The microbicidal effect of low-temperature plasma generated by corona discharge: Comparison of various microorganisms on an agar surface or in aqueous suspension. Plasma Process. Polym. 2010, 7, 237–243. [Google Scholar] [CrossRef]
- Scholtz, V.; Kvasnickova, E.; Julak, J. Microbial Inactivation by Electric Discharge with Metallic Grid. Acta Phys. Pol. A 2013, 124, 62–65. [Google Scholar] [CrossRef]
- Švarcová, M.J.J.; Hubka, V.; Soušková, H.; Scholtz, V. Treatment of a superficial mycosis by low-temperature plasma: A case report. Prague Med. Rep. 2014, 115, 73–78. [Google Scholar] [CrossRef][Green Version]
- Vankova, E.; Valkova, M.; Kasparova, P.; Masak, J.; Scholtz, V.; Khun, J.; Julak, J. Prevention of biofilm re-development on Ti-6Al-4V alloy by cometary discharge with a metallic grid. Contrib. Plasm. Phys. 2019, 59, 166–172. [Google Scholar] [CrossRef]
- Lokajová, E.; Julák, J.; Khun, J.; Soušková, H.; Dobiáš, R.; Lux, J.; Scholtz, V. Inactivation of Dermatophytes Causing Onychomycosis Using Non-Thermal Plasma as a Prerequisite for Therapy. J. Fungi 2021, 7, 715. [Google Scholar] [CrossRef]
- Lux, J.; Dobias, R.; Kuklova, I.; Litvik, R.; Scholtz, V.; Souskova, H.; Khun, J.; Mrazek, J.; Kantorova, M.; Jaworska, P.; et al. Inactivation of Dermatophytes Causing Onychomycosis and Its Therapy Using Non-Thermal Plasma. J. Fungi 2020, 6, 214. [Google Scholar] [CrossRef]
- Laher, R.R.; Gilmore, F.R. Improved fits for the vibrational and rotational constants of many states of nitrogen and oxygen. J. Phys. Chem. Ref. Data 1991, 20, 685–712. [Google Scholar] [CrossRef]
- Ventura, L.R.; Fellows, C.E. The N2 second positive (C3Πu → B3Πg) system reviewed: Improved data and analysis. J. Quant. Spectrosc. Radiat. Transf. 2019, 239, 106645. [Google Scholar] [CrossRef]
- Bashir, M.; Rees, J.M.; Bashir, S.; Zimmerman, W.B. Characterization of atmospheric pressure microplasma produced from argon and a mixture of argon–ethylenediamine. Phys. Lett. A 2014, 378, 2395–2405. [Google Scholar] [CrossRef]
- Zhang, Q.Y.; Shi, D.Q.; Xu, W.; Miao, C.Y.; Ma, C.Y.; Ren, C.S.; Zhang, C.; Yi, Z. Determination of vibrational and rotational temperatures in highly constricted nitrogen plasmas by fitting the second positive system of N2 molecules. Aip Adv. 2015, 5, 057158. [Google Scholar] [CrossRef]
- Gilmore, F.R.; Laher, R.R.; Espy, P.J. Franck–Condon factors, r-centroids, electronic transition moments, and Einstein coefficients for many nitrogen and oxygen band systems. J. Phys. Chem. Ref. Data 1992, 21, 1005–1107. [Google Scholar] [CrossRef]
- Deng, X.L.; Nikiforov, A.Y.; Vanraes, P.; Leys, C. Direct current plasma jet at atmospheric pressure operating in nitrogen and air. J. Appl. Phys. 2013, 113, 023305. [Google Scholar] [CrossRef]
- Akishev, Y.; Grushin, M.; Karalnik, V.; Petryakov, A.; Trushkin, N. Non-equilibrium constricted dc glow discharge in N2 flow at atmospheric pressure: Stable and unstable regimes. J. Quant. Spectrosc. Radiat. Transf. 2010, 43, 075202. [Google Scholar]
- Callebaut, T.; Kochetov, I.; Akishev, Y.; Napartovich, A.; Leys, C. Numerical simulation and experimental study of the corona and glow regime of a negative pin-to-plate discharge in flowing ambient air. Plasma Sources Sci. Technol. 2004, 13, 245–250. [Google Scholar] [CrossRef]
- Kossyi, I.A.; Kostinsky, A.Y.; Matveyev, A.A.; Silakov, V.P. Kinetic scheme of the non-equilibrium discharge in nitrogen-oxygen mixtures. Plasma Sources Sci. Technol. 1992, 1, 207–220. [Google Scholar] [CrossRef]
- Cernogora, G.; Hochard, L.; Touzeau, M.; Ferreira, C.M. Population of N2 (A 3Σu+) metastable states in a pure nitrogen glow discharge. J. Phys. B At. Mol. Opt. 1981, 14, 2977–2987. [Google Scholar] [CrossRef]
- Itikawa, Y. Cross sections for electron collisions with nitrogen molecules. J. Phys. Chem. Ref. Data 2006, 35, 31–53. [Google Scholar] [CrossRef]
- Lu, X.; Naidis, G.V.; Laroussi, M.; Reuter, S.; Graves, D.B.; Ostrikov, K. Reactive species in non-equilibrium atmospheric-pressure plasmas: Generation, transport, and biological effects. Phys. Rep. 2016, 630, 1–84. [Google Scholar] [CrossRef]
- Guerra, V.; Sa, P.A.; Loureiro, J. Role played by the N2 (A3Σu+) metastable in stationary N2 and N2-O2 discharges. J. Phys. D Appl. Phys. 2001, 34, 1745–1755. [Google Scholar] [CrossRef]
- Van Gaens, W.; Iseni, S.; Schmidt-Bleker, A.; Weltmann, K.D.; Reuter, S.; Bogaerts, A. Numerical analysis of the effect of nitrogen and oxygen admixtures on the chemistry of an argon plasma jet operating at atmospheric pressure. New J. Phys. 2015, 17, 033003. [Google Scholar] [CrossRef]
- Ono, R. Optical diagnostics of reactive species in atmospheric-pressure nonthermal plasma. J. Phys. D Appl. Phys. 2016, 49, 083001. [Google Scholar] [CrossRef]
- Liu, F.; Wang, W.; Zheng, W.; Wang, Y. Investigation of spatially resolved spectra of OH and N2+ in N2 and H2O mixture wire-plate positive pulsed streamer discharge. Spectrochim. Acta A 2008, 69, 776–781. [Google Scholar] [CrossRef] [PubMed]
- Alkawareek, M.Y.; Gorman, S.P.; Graham, W.G.; Gilmore, B. Potential cellular targets and antibacterial efficacy of atmospheric pressure non-thermal plasma. Int. J. Antimicrob. Agents 2014, 43, 154–160. [Google Scholar] [CrossRef]
- Daeschlein, G.; Napp, M.; von Podewils, S.; Lutze, S.; Emmert, S.; Lange, A.; Klare, I.; Haase, H.; Gumbel, D.; von Woedtke, T.; et al. In vitro susceptibility of multidrug resistant skin and wound pathogens against low temperature atmospheric pressure plasma jet (APPJ) and dielectric barrier discharge plasma (DBD). Plasma Process. Polym. 2014, 11, 175–183. [Google Scholar] [CrossRef]
- Flynn, P.B.; Higginbotham, S.; Nid’a, H.A.; Gorman, S.P.; Graham, W.G.; Gilmore, B.F. Bactericidal efficacy of atmospheric pressure non-thermal plasma (APNTP) against the ESKAPE pathogens. Int. J. Antimicrob. Agents 2015, 46, 101–107. [Google Scholar] [CrossRef]
- Lunov, O.; Zablotskii, V.; Churpita, O.; Jäger, A.; Polívka, L.; Syková, E.; Terebova, N.; Kulikov, A.; Kubinova, S.; Dejneka, A. Towards the understanding of non-thermal air plasma action: Effects on bacteria and fibroblasts. Rsc Adv. 2016, 6, 25286–25292. [Google Scholar] [CrossRef]
- Heller, L.C.; Edelblute, C.M.; Mattson, A.M.; Hao, X.; Kolb, J.F. Inactivation of bacterial opportunistic skin pathogens by nonthermal DC-operated afterglow atmospheric plasma. Lett. Appl. Microbiol. 2012, 54, 126–132. [Google Scholar] [CrossRef]
- Choi, E.J.; Yang, H.S.; Park, H.W.; Chun, H.H. Inactivation of Escherichia coli O157: H7 and Staphylococcus aureus in red pepper powder using a combination of radio frequency thermal and indirect dielectric barrier discharge plasma non-thermal treatments. Lwt-Food Sci. Technol. 2018, 93, 477–484. [Google Scholar] [CrossRef]
- Yong, H.I.; Lee, S.H.; Kim, S.Y. Park, S.; Park, J.; Choe, W.; Jo, C. Color development, physiochemical properties, and microbiological safety of pork jerky processed with atmospheric pressure plasma. Innov. Food Sci. Emerg. 2019, 53, 78–84. [Google Scholar] [CrossRef]
- Julák, J.; Janoušková, O.; Scholtz, V.; Holada, K. Inactivation of prions using electrical DC discharges at atmospheric pressure and ambient temperature. Plasma Process. Polym. 2011, 8, 316–323. [Google Scholar] [CrossRef]
- Graves, D.B. The emerging role of reactive oxygen and nitrogen species in redox biology and some implications for plasma applications to medicine and biology. J. Phys. D Appl. Phys. 2012, 45, 263001. [Google Scholar] [CrossRef]
- Kelly, S.; Turner, M.M. Atomic oxygen patterning from a biomedical needle-plasma source. J. Appl. Phys. 2013, 114, 123301. [Google Scholar] [CrossRef]
- Sysolyatina, E.; Mukhachev, A.; Yurova, M.; Grushin, M.; Karalnik, V.; Petryakov, A.; Trushkin, N.; Ermolaeva, S.; Akishev, Y. Role of the charged particles in bacteria inactivation by plasma of a positive and negative corona in ambient air. Plasma Process. Polym. 2014, 11, 315–334. [Google Scholar] [CrossRef]
- Liu, D.X.; Liu, Z.C.; Chen, C.; Yang, A.J.; Li, D.; Rong, M.Z.; Chen, H.L.; Kong, M.G. Aqueous reactive species induced by a surface air discharge: Heterogeneous mass transfer and liquid chemistry pathways. Sci. Rep. 2016, 6, 23737. [Google Scholar] [CrossRef]
- Schneider, S.; Lackmann, J.W.; Ellerweg, D.; Denis, B.; Narberhaus, F.; Bandow, J.E.; Benedikt, J. The role of VUV radiation in the inactivation of bacteria with an atmospheric pressure plasma jet. Plasma Process. Polym. 2012, 9, 561–568. [Google Scholar] [CrossRef]
- Pavlovich, M.J.; Sakiyama, Y.; Clark, D.S.; Graves, D.B. Antimicrobial Synergy Between Ambient-G as Plasma and UVA Treatment of Aqueous Solution. Plasma Process. Polym. 2013, 10, 1051–1060. [Google Scholar] [CrossRef]
- Oehmigen, K.; Hähnel, M.; Brandenburg, R.; Wilke, C.; Weltmann, K.D.; Von Woedtke, T. The role of acidification for antimicrobial activity of atmospheric pressure plasma in liquids. Plasma Process. Polym. 2010, 7, 250–257. [Google Scholar] [CrossRef]
- Machala, Z.; Chládeková, L.; Pelach, M. Plasma agents in bio-decontamination by dc discharges in atmospheric air. J. Phys. D Appl. Phys. 2010, 43, 222001. [Google Scholar] [CrossRef]
- Dobrynin, D.; Friedman, G.; Fridman, A.; Starikovskiy, A. Inactivation of bacteria using dc corona discharge: Role of ions and humidity. New J. Phys. 2011, 13, 103033. [Google Scholar] [CrossRef] [PubMed]
- Stoffels, E.; Sakiyama, Y.; Graves, D.B. Cold atmospheric plasma: Charged species and their interactions with cells and tissues. IEEE Trans. Plasma Sci. 2008, 36, 1441–1457. [Google Scholar] [CrossRef]
- Dobrynin, D.; Fridman, G.; Friedman, G.; Fridman, A. Physical and biological mechanisms of direct plasma interaction with living tissue. New J. Phys. 2009, 11, 115020. [Google Scholar] [CrossRef]
- Laroussi, M.; Leipold, F. Evaluation of the roles of reactive species, heat, and UV radiation in the inactivation of bacterial cells by air plasmas at atmospheric pressure. Int. J. Mass Spectrom. 2004, 233, 81–86. [Google Scholar] [CrossRef]
- Stoffels, E. Gas plasmas in biology and medicine. J. Phys. D Appl. Phys. 2006, 39, 1. [Google Scholar] [CrossRef]

| Discharge | Cometary | Point-to-Ring | |||||||||
|---|---|---|---|---|---|---|---|---|---|---|---|
| Exposure Time (min) | 0 | 5 | 15 | 30 | 60 | 0 | 5 | 15 | 30 | 60 | |
| S. aureus ATCC 12600 | 0 | 12 | 19 | 20 | 23 | 0 | 0 | 31 | 39 | 40 | |
| S. aureus (MRSA) ATCC 14330 | 0 | 8 | 19 | 21 | 24 | 0 | 0 | 45 | 55 | 56 | |
| MRSA (M) | 0 | 20 | 21 | 24 | 31 | 0 | 0 | 24 | 35 | 40 | |
| P. aeruginosa PA01 | 0 | 4 | 16 | 18 | 24 | 0 | 0 | 0 | 16 | 36 | |
| P. aeruginosa (L) | 0 | 10 | 18 | 25 | 28 | 0 | 0 | 21 | 45 | 49 | |
| P. aeruginosa DBM 3181 | 0 | 13 | 20 | 24 | 28 | 0 | 0 | 46 | 53 | 53 | |
| C. albicans ATCC MYA-2876 | 0 | 4 | 5 | 16 | 20 | 0 | 31 | 44 | 48 | 40 | |
| C. albicans F7-39/IDE99 | 0 | 4 | 12 | 22 | 24 | 0 | 17 | 26 | 32 | 34 | |
| C. albicans N-873 | 0 | 0 | 13 | 15 | 16 | 0 | 0 | 0 | 15 | 40 | |
| T. interdigitale 6603 | 0 | 27 | 41 | 51 | 54 | 0 | 0 | 14 | 37 | 45 | |
| T. interdigitale 8776 | 0 | 23 | 39 | 50 | 52 | 0 | 0 | 6 | 18 | 16 | |
| T. interdigitale 8488 | 0 | 30 | 43 | 51 | 51 | 0 | 0 | 7 | 26 | 33 | |
| Discharge | Cometary | Point-to-Ring | |||||||||
|---|---|---|---|---|---|---|---|---|---|---|---|
| Exposure Time (min) | 0 | 5 | 15 | 30 | 60 | 0 | 5 | 15 | 30 | 60 | |
| S. aureus ATCC 12600 | 0 | 0 | 1 | 3 | 10 | 0 | 0 | 0 | 6 | 14 | |
| S. aureus (MRSA) ATCC 14330 | 0 | 0 | 0 | 18 | 24 | 0 | 0 | 0 | 0 | 0 | |
| MRSA (M) | 0 | 0 | 0 | 3 | 4 | 0 | 0 | 0 | 3 | 3 | |
| P. aeruginosa PA01 | 0 | 0 | 1 | 2 | 7 | 0 | 0 | 0 | 0 | 5 | |
| P. aeruginosa (L) | 0 | 0 | 3 | 12 | 18 | 0 | 0 | 0 | 3 | 17 | |
| P. aeruginosa DBM 3181 | 0 | 0 | 1 | 4 | 17 | 0 | 0 | 0 | 1 | 28 | |
| C. albicans ATCC MYA-2876 | 0 | 4 | 5 | 13 | 20 | 0 | 6 | 14 | 24 | 36 | |
| C. albicans F7-39/IDE99 | 0 | 4 | 12 | 22 | 24 | 0 | 15 | 26 | 32 | 34 | |
| C. albicans N-873 | 0 | 0 | 5 | 10 | 16 | 0 | 0 | 0 | 15 | 40 | |
| T. interdigitale 6603 | 0 | 16 | 39 | 51 | 54 | 0 | 0 | 0 | 16 | 40 | |
| T. interdigitale 8776 | 0 | 0 | 1 | 13 | 20 | 0 | 0 | 0 | 0 | 0 | |
| T. interdigitale 8488 | 0 | 1 | 1 | 9 | 16 | 0 | 0 | 0 | 0 | 7 | |
Publisher’s Note: MDPI stays neutral with regard to jurisdictional claims in published maps and institutional affiliations. |
© 2021 by the authors. Licensee MDPI, Basel, Switzerland. This article is an open access article distributed under the terms and conditions of the Creative Commons Attribution (CC BY) license (https://creativecommons.org/licenses/by/4.0/).
Share and Cite
Khun, J.; Machková, A.; Kašparová, P.; Klenivskyi, M.; Vaňková, E.; Galář, P.; Julák, J.; Scholtz, V. Non-Thermal Plasma Sources Based on Cometary and Point-to-Ring Discharges. Molecules 2022, 27, 238. https://doi.org/10.3390/molecules27010238
Khun J, Machková A, Kašparová P, Klenivskyi M, Vaňková E, Galář P, Julák J, Scholtz V. Non-Thermal Plasma Sources Based on Cometary and Point-to-Ring Discharges. Molecules. 2022; 27(1):238. https://doi.org/10.3390/molecules27010238
Chicago/Turabian StyleKhun, Josef, Anna Machková, Petra Kašparová, Myron Klenivskyi, Eva Vaňková, Pavel Galář, Jaroslav Julák, and Vladimír Scholtz. 2022. "Non-Thermal Plasma Sources Based on Cometary and Point-to-Ring Discharges" Molecules 27, no. 1: 238. https://doi.org/10.3390/molecules27010238
APA StyleKhun, J., Machková, A., Kašparová, P., Klenivskyi, M., Vaňková, E., Galář, P., Julák, J., & Scholtz, V. (2022). Non-Thermal Plasma Sources Based on Cometary and Point-to-Ring Discharges. Molecules, 27(1), 238. https://doi.org/10.3390/molecules27010238

